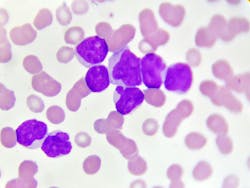
665f29fc8732baaffee197ca Dreamstime Xxl 99238672 665f29fc8732baaffee197ca Dreamstime Xxl 99238672

Qlucore starts project after receiving prestigious EU grant to advance personalized cancer treatment
Qlucore has passed the evaluation phase and will receive a EIC Accelerator grant of 2,5 million Euros to accelerate the development of clinical cancer diagnostics solutions for acute myeloid leukemia (AML) as well as bladder cancer.
In March the grant was made public and Qlucore is now starting the project and has received the first payment.
During the project Qlucore will develop and launch CE-marked software for clinical cancer diagnostics for the two cancer types. The project will stretch over three years, with objectives to develop solutions for use by clinical laboratories as well as companion diagnostics (CDx) solutions in collaboration with pharma companies.
Intended customers are clinical laboratories in Europe in the first phase and the US market in a second phase.